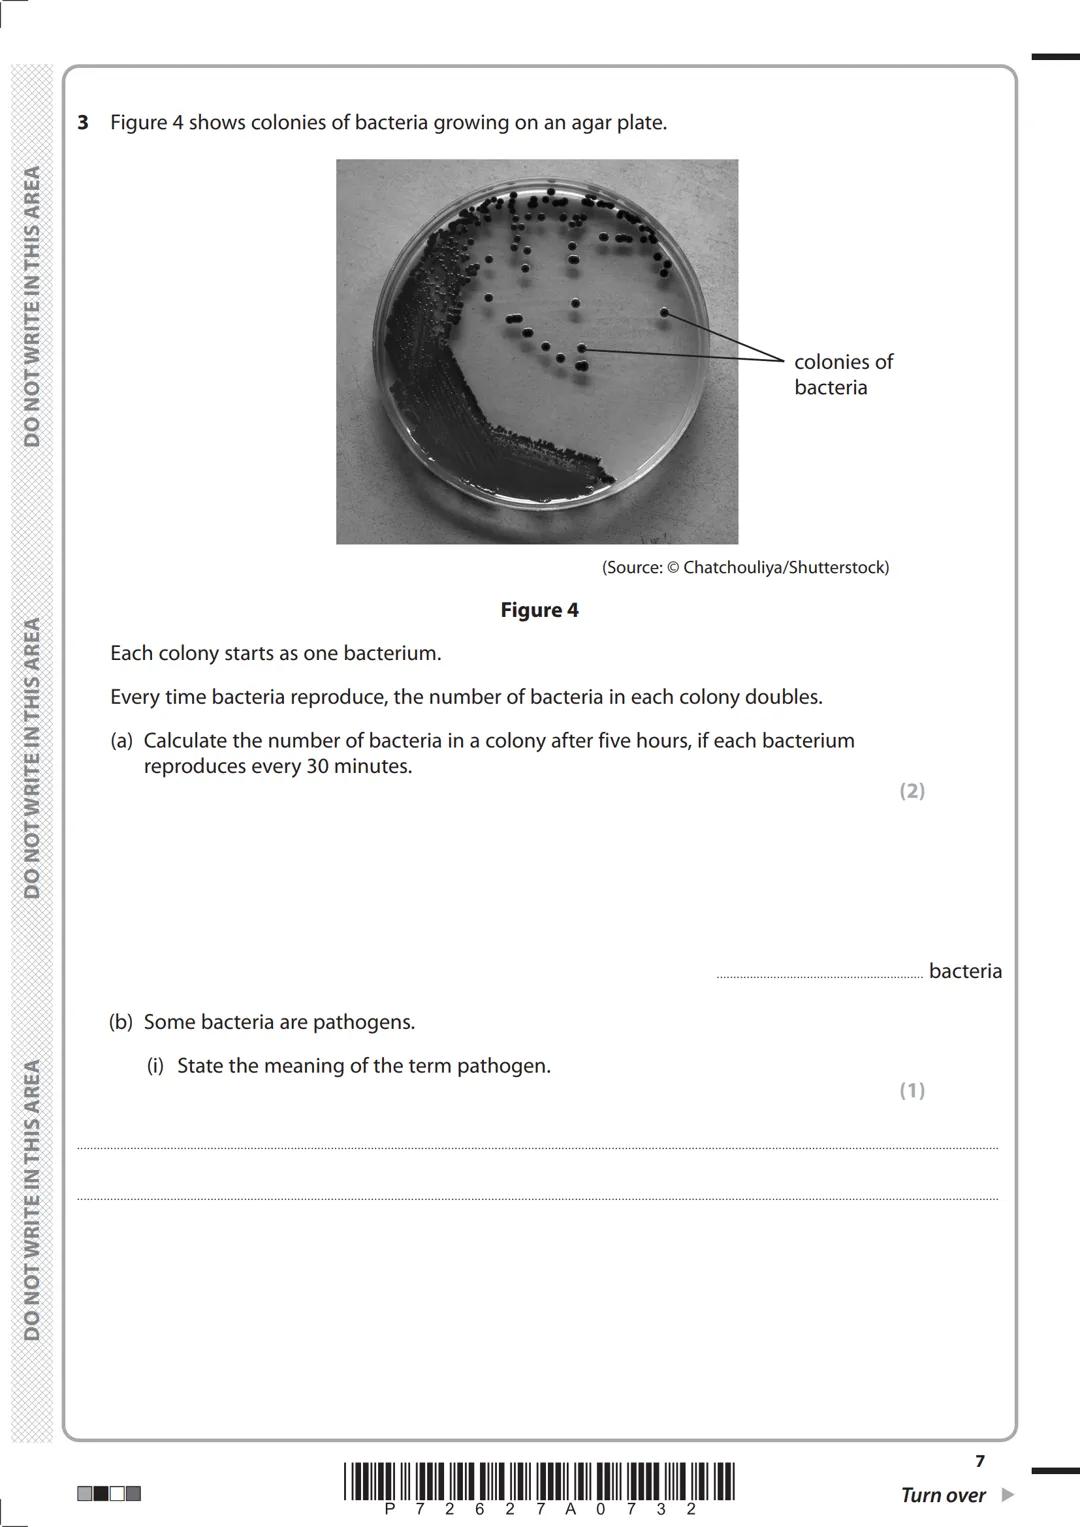
Please check the examination details below before entering your candidate information
Other names
Candidate surname
Centre Number
Candidate

This is your complete guide to the Edexcel GCSE Biology... Show more
Sign up to see the contentIt's free!
Access to all documents
Improve your grades
Join milions of students
Knowunity AI
Subjects
Triangle Congruence and Similarity Theorems
Triangle Properties and Classification
Linear Equations and Graphs
Geometric Angle Relationships
Trigonometric Functions and Identities
Equation Solving Techniques
Circle Geometry Fundamentals
Division Operations and Methods
Basic Differentiation Rules
Exponent and Logarithm Properties
Show all topics
Human Organ Systems
Reproductive Cell Cycles
Biological Sciences Subdisciplines
Cellular Energy Metabolism
Autotrophic Energy Processes
Inheritance Patterns and Principles
Biomolecular Structure and Organization
Cell Cycle and Division Mechanics
Cellular Organization and Development
Biological Structural Organization
Show all topics
Chemical Sciences and Applications
Atomic Structure and Composition
Molecular Electron Structure Representation
Atomic Electron Behavior
Matter Properties and Water
Mole Concept and Calculations
Gas Laws and Behavior
Periodic Table Organization
Chemical Thermodynamics Fundamentals
Chemical Bond Types and Properties
Show all topics
European Renaissance and Enlightenment
European Cultural Movements 800-1920
American Revolution Era 1763-1797
American Civil War 1861-1865
Global Imperial Systems
Mongol and Chinese Dynasties
U.S. Presidents and World Leaders
Historical Sources and Documentation
World Wars Era and Impact
World Religious Systems
Show all topics
Classic and Contemporary Novels
Literary Character Analysis
Rhetorical Theory and Practice
Classic Literary Narratives
Reading Analysis and Interpretation
Narrative Structure and Techniques
English Language Components
Influential English-Language Authors
Basic Sentence Structure
Narrative Voice and Perspective
Show all topics
490
•
Updated Apr 5, 2026
•
henry
@henryhenry134
This is your complete guide to the Edexcel GCSE Biology... Show more











This is a Higher Tier GCSE Biology exam worth 100 marks total with 1 hour 45 minutes to complete it. You'll need a ruler and calculator, plus black ink or a ballpoint pen.
The exam covers multiple biology topics with questions marked in brackets showing how many marks each is worth. Questions with an asterisk (*) need you to structure your answers logically, showing how your points connect to each other.
💡 Top tip: Use the mark allocation as your time guide - don't spend ages on a 1-mark question when there are 6-mark questions waiting!

Ever wondered how scientists measure the energy content in your favourite biscuits? They use a bomb calorimeter - a clever device that burns food samples in water and measures the temperature rise.
The key equation you need to remember is: energy content = (mass of water × temperature rise × 4.2) ÷ mass of food. When a biscuit burns and releases more energy, it causes a greater temperature rise in the surrounding water.
💡 Remember: Bomb calorimeters give more accurate results than simple school lab equipment because they prevent heat loss to the surroundings, ensuring all the energy from burning food heats the water.

Using the bomb calorimeter equation with real data helps you understand energy calculations. For example, with 1000g of water, a temperature rise of 69.4°C, and a 14.7g biscuit, you can work out the exact energy content per gram.
Different biscuits with the same mass can give different temperature rises. A higher temperature rise means that biscuit contains more energy per gram - perhaps it has more fat or sugar, which are high-energy compounds.
💡 Practice tip: Always check your units match the equation - masses in grams, temperature in °C, and your final answer in J/g.

Bomb calorimeters beat simple school lab equipment hands down for accuracy. In school labs, loads of heat escapes to the air around the experiment, giving you a much lower reading than the food actually contains.
Professional bomb calorimeters are sealed systems that capture virtually all the heat energy released. This means scientists get reliable, repeatable results that food manufacturers can use on nutrition labels.
💡 Key point: Always mention "heat loss to surroundings" when comparing these two methods - it's the main reason for the difference in accuracy.

Asexual reproduction produces genetically identical organisms - no mixing of genes from two parents needed. Grafting in apple trees is a perfect example, where shoots are attached to rootstocks to create identical trees.
Growing genetically identical apple trees has clear advantages and disadvantages. You might get consistent, high-quality fruit (advantage), but if disease strikes, it could wipe out your entire crop since all trees have identical defences (disadvantage).
💡 Think about it: Genetic diversity usually helps species survive - so when might genetic uniformity actually be useful?

As apples ripen, enzymes convert starch into sugars - that's why ripe apples taste sweeter! Each enzyme works best at its optimum pH, and designing experiments to find this teaches you proper scientific method.
To test enzyme activity, you'd set up multiple test tubes with the same enzyme and starch concentrations but different pH levels. Use iodine solution to test for starch - it turns blue-black when starch is present and stays orange-brown when starch has been broken down.
💡 Method tip: At pH 10, enzymes stop working because the alkaline conditions change their shape permanently - this is called denaturation and it's irreversible.

Bacterial colonies start from single cells that multiply incredibly fast through binary fission - they literally split in two! If bacteria reproduce every 30 minutes, one bacterium becomes over 1000 bacteria in just 5 hours.
Pathogens are microorganisms that cause disease in other living things. Many bacteria are harmless or even helpful, but pathogenic bacteria can make you seriously ill by producing toxins or damaging your tissues.
💡 Quick calculation: Remember that doubling every 30 minutes means 2¹⁰ bacteria after 5 hours (that's 1024 bacteria from one original cell!).

Antibiotics work brilliantly against bacterial infections because they target specific features that bacteria have but human cells don't. They might stop bacteria making cell walls or prevent them from reproducing.
Magnification calculations are straightforward once you remember the formula: magnification = image size ÷ actual size. A 0.005mm bacterium drawn as 80mm long gives you a magnification of ×16,000.
💡 Remember: Antibiotics only work on bacteria, not viruses - that's why your doctor won't prescribe them for a common cold!

Vision charts help opticians diagnose eye problems by testing how well you can see letters at different sizes. Short-sightedness happens when your eyeball is too long or your lens is too curved, making distant objects appear blurry.
Calculating percentages in biology contexts is common - if 35% of 240 people have normal vision, then 65% (that's 156 people) need glasses to correct their eyesight.
💡 Real-world connection: Short-sightedness is becoming more common, especially among young people who spend lots of time looking at screens and books up close.

Short-sightedness correction requires concave lenses that spread light rays out before they enter your eye. This moves the focused image back onto your retina where it should be, making distant objects appear sharp again.
The diagrams show different lens types and how they affect light rays. Understanding whether you need light rays to converge (come together) or diverge (spread apart) helps you choose the right correction method.
💡 Memory trick: Short-sighted people need to "spread out" the light with concave lenses - think "spreading out" to see things that are "spread out" (far away).
Our AI Companion is a student-focused AI tool that offers more than just answers. Built on millions of Knowunity resources, it provides relevant information, personalised study plans, quizzes, and content directly in the chat, adapting to your individual learning journey.
You can download the app from Google Play Store and Apple App Store.
That's right! Enjoy free access to study content, connect with fellow students, and get instant help – all at your fingertips.
App Store
Google Play
The app is very easy to use and well designed. I have found everything I was looking for so far and have been able to learn a lot from the presentations! I will definitely use the app for a class assignment! And of course it also helps a lot as an inspiration.
Stefan S
iOS user
This app is really great. There are so many study notes and help [...]. My problem subject is French, for example, and the app has so many options for help. Thanks to this app, I have improved my French. I would recommend it to anyone.
Samantha Klich
Android user
Wow, I am really amazed. I just tried the app because I've seen it advertised many times and was absolutely stunned. This app is THE HELP you want for school and above all, it offers so many things, such as workouts and fact sheets, which have been VERY helpful to me personally.
Anna
iOS user
Best app on earth! no words because it’s too good
Thomas R
iOS user
Just amazing. Let's me revise 10x better, this app is a quick 10/10. I highly recommend it to anyone. I can watch and search for notes. I can save them in the subject folder. I can revise it any time when I come back. If you haven't tried this app, you're really missing out.
Basil
Android user
This app has made me feel so much more confident in my exam prep, not only through boosting my own self confidence through the features that allow you to connect with others and feel less alone, but also through the way the app itself is centred around making you feel better. It is easy to navigate, fun to use, and helpful to anyone struggling in absolutely any way.
David K
iOS user
The app's just great! All I have to do is enter the topic in the search bar and I get the response real fast. I don't have to watch 10 YouTube videos to understand something, so I'm saving my time. Highly recommended!
Sudenaz Ocak
Android user
In school I was really bad at maths but thanks to the app, I am doing better now. I am so grateful that you made the app.
Greenlight Bonnie
Android user
very reliable app to help and grow your ideas of Maths, English and other related topics in your works. please use this app if your struggling in areas, this app is key for that. wish I'd of done a review before. and it's also free so don't worry about that.
Rohan U
Android user
I know a lot of apps use fake accounts to boost their reviews but this app deserves it all. Originally I was getting 4 in my English exams and this time I got a grade 7. I didn’t even know about this app three days until the exam and it has helped A LOT. Please actually trust me and use it as I’m sure you too will see developments.
Xander S
iOS user
THE QUIZES AND FLASHCARDS ARE SO USEFUL AND I LOVE Knowunity AI. IT ALSO IS LITREALLY LIKE CHATGPT BUT SMARTER!! HELPED ME WITH MY MASCARA PROBLEMS TOO!! AS WELL AS MY REAL SUBJECTS ! DUHHH 😍😁😲🤑💗✨🎀😮
Elisha
iOS user
This apps acc the goat. I find revision so boring but this app makes it so easy to organize it all and then you can ask the freeeee ai to test yourself so good and you can easily upload your own stuff. highly recommend as someone taking mocks now
Paul T
iOS user
The app is very easy to use and well designed. I have found everything I was looking for so far and have been able to learn a lot from the presentations! I will definitely use the app for a class assignment! And of course it also helps a lot as an inspiration.
Stefan S
iOS user
This app is really great. There are so many study notes and help [...]. My problem subject is French, for example, and the app has so many options for help. Thanks to this app, I have improved my French. I would recommend it to anyone.
Samantha Klich
Android user
Wow, I am really amazed. I just tried the app because I've seen it advertised many times and was absolutely stunned. This app is THE HELP you want for school and above all, it offers so many things, such as workouts and fact sheets, which have been VERY helpful to me personally.
Anna
iOS user
Best app on earth! no words because it’s too good
Thomas R
iOS user
Just amazing. Let's me revise 10x better, this app is a quick 10/10. I highly recommend it to anyone. I can watch and search for notes. I can save them in the subject folder. I can revise it any time when I come back. If you haven't tried this app, you're really missing out.
Basil
Android user
This app has made me feel so much more confident in my exam prep, not only through boosting my own self confidence through the features that allow you to connect with others and feel less alone, but also through the way the app itself is centred around making you feel better. It is easy to navigate, fun to use, and helpful to anyone struggling in absolutely any way.
David K
iOS user
The app's just great! All I have to do is enter the topic in the search bar and I get the response real fast. I don't have to watch 10 YouTube videos to understand something, so I'm saving my time. Highly recommended!
Sudenaz Ocak
Android user
In school I was really bad at maths but thanks to the app, I am doing better now. I am so grateful that you made the app.
Greenlight Bonnie
Android user
very reliable app to help and grow your ideas of Maths, English and other related topics in your works. please use this app if your struggling in areas, this app is key for that. wish I'd of done a review before. and it's also free so don't worry about that.
Rohan U
Android user
I know a lot of apps use fake accounts to boost their reviews but this app deserves it all. Originally I was getting 4 in my English exams and this time I got a grade 7. I didn’t even know about this app three days until the exam and it has helped A LOT. Please actually trust me and use it as I’m sure you too will see developments.
Xander S
iOS user
THE QUIZES AND FLASHCARDS ARE SO USEFUL AND I LOVE Knowunity AI. IT ALSO IS LITREALLY LIKE CHATGPT BUT SMARTER!! HELPED ME WITH MY MASCARA PROBLEMS TOO!! AS WELL AS MY REAL SUBJECTS ! DUHHH 😍😁😲🤑💗✨🎀😮
Elisha
iOS user
This apps acc the goat. I find revision so boring but this app makes it so easy to organize it all and then you can ask the freeeee ai to test yourself so good and you can easily upload your own stuff. highly recommend as someone taking mocks now
Paul T
iOS user
henry
@henryhenry134
This is your complete guide to the Edexcel GCSE Biology Paper 1 exam from May 2023. You'll find everything from measuring energy in food using bomb calorimeters to understanding bacterial reproduction and correcting vision problems.

Access to all documents
Improve your grades
Join milions of students
This is a Higher Tier GCSE Biology exam worth 100 marks total with 1 hour 45 minutes to complete it. You'll need a ruler and calculator, plus black ink or a ballpoint pen.
The exam covers multiple biology topics with questions marked in brackets showing how many marks each is worth. Questions with an asterisk (*) need you to structure your answers logically, showing how your points connect to each other.
💡 Top tip: Use the mark allocation as your time guide - don't spend ages on a 1-mark question when there are 6-mark questions waiting!

Access to all documents
Improve your grades
Join milions of students
Ever wondered how scientists measure the energy content in your favourite biscuits? They use a bomb calorimeter - a clever device that burns food samples in water and measures the temperature rise.
The key equation you need to remember is: energy content = (mass of water × temperature rise × 4.2) ÷ mass of food. When a biscuit burns and releases more energy, it causes a greater temperature rise in the surrounding water.
💡 Remember: Bomb calorimeters give more accurate results than simple school lab equipment because they prevent heat loss to the surroundings, ensuring all the energy from burning food heats the water.

Access to all documents
Improve your grades
Join milions of students
Using the bomb calorimeter equation with real data helps you understand energy calculations. For example, with 1000g of water, a temperature rise of 69.4°C, and a 14.7g biscuit, you can work out the exact energy content per gram.
Different biscuits with the same mass can give different temperature rises. A higher temperature rise means that biscuit contains more energy per gram - perhaps it has more fat or sugar, which are high-energy compounds.
💡 Practice tip: Always check your units match the equation - masses in grams, temperature in °C, and your final answer in J/g.

Access to all documents
Improve your grades
Join milions of students
Bomb calorimeters beat simple school lab equipment hands down for accuracy. In school labs, loads of heat escapes to the air around the experiment, giving you a much lower reading than the food actually contains.
Professional bomb calorimeters are sealed systems that capture virtually all the heat energy released. This means scientists get reliable, repeatable results that food manufacturers can use on nutrition labels.
💡 Key point: Always mention "heat loss to surroundings" when comparing these two methods - it's the main reason for the difference in accuracy.

Access to all documents
Improve your grades
Join milions of students
Asexual reproduction produces genetically identical organisms - no mixing of genes from two parents needed. Grafting in apple trees is a perfect example, where shoots are attached to rootstocks to create identical trees.
Growing genetically identical apple trees has clear advantages and disadvantages. You might get consistent, high-quality fruit (advantage), but if disease strikes, it could wipe out your entire crop since all trees have identical defences (disadvantage).
💡 Think about it: Genetic diversity usually helps species survive - so when might genetic uniformity actually be useful?

Access to all documents
Improve your grades
Join milions of students
As apples ripen, enzymes convert starch into sugars - that's why ripe apples taste sweeter! Each enzyme works best at its optimum pH, and designing experiments to find this teaches you proper scientific method.
To test enzyme activity, you'd set up multiple test tubes with the same enzyme and starch concentrations but different pH levels. Use iodine solution to test for starch - it turns blue-black when starch is present and stays orange-brown when starch has been broken down.
💡 Method tip: At pH 10, enzymes stop working because the alkaline conditions change their shape permanently - this is called denaturation and it's irreversible.
Access to all documents
Improve your grades
Join milions of students
Bacterial colonies start from single cells that multiply incredibly fast through binary fission - they literally split in two! If bacteria reproduce every 30 minutes, one bacterium becomes over 1000 bacteria in just 5 hours.
Pathogens are microorganisms that cause disease in other living things. Many bacteria are harmless or even helpful, but pathogenic bacteria can make you seriously ill by producing toxins or damaging your tissues.
💡 Quick calculation: Remember that doubling every 30 minutes means 2¹⁰ bacteria after 5 hours (that's 1024 bacteria from one original cell!).

Access to all documents
Improve your grades
Join milions of students
Antibiotics work brilliantly against bacterial infections because they target specific features that bacteria have but human cells don't. They might stop bacteria making cell walls or prevent them from reproducing.
Magnification calculations are straightforward once you remember the formula: magnification = image size ÷ actual size. A 0.005mm bacterium drawn as 80mm long gives you a magnification of ×16,000.
💡 Remember: Antibiotics only work on bacteria, not viruses - that's why your doctor won't prescribe them for a common cold!

Access to all documents
Improve your grades
Join milions of students
Vision charts help opticians diagnose eye problems by testing how well you can see letters at different sizes. Short-sightedness happens when your eyeball is too long or your lens is too curved, making distant objects appear blurry.
Calculating percentages in biology contexts is common - if 35% of 240 people have normal vision, then 65% (that's 156 people) need glasses to correct their eyesight.
💡 Real-world connection: Short-sightedness is becoming more common, especially among young people who spend lots of time looking at screens and books up close.

Access to all documents
Improve your grades
Join milions of students
Short-sightedness correction requires concave lenses that spread light rays out before they enter your eye. This moves the focused image back onto your retina where it should be, making distant objects appear sharp again.
The diagrams show different lens types and how they affect light rays. Understanding whether you need light rays to converge (come together) or diverge (spread apart) helps you choose the right correction method.
💡 Memory trick: Short-sighted people need to "spread out" the light with concave lenses - think "spreading out" to see things that are "spread out" (far away).
Our AI Companion is a student-focused AI tool that offers more than just answers. Built on millions of Knowunity resources, it provides relevant information, personalised study plans, quizzes, and content directly in the chat, adapting to your individual learning journey.
You can download the app from Google Play Store and Apple App Store.
That's right! Enjoy free access to study content, connect with fellow students, and get instant help – all at your fingertips.
4
Smart Tools NEW
Transform this note into: ✓ 50+ Practice Questions ✓ Interactive Flashcards ✓ Full Mock Exam ✓ Essay Outlines
Explore the mechanisms of infection and the immune response in this comprehensive overview. Learn about different types of pathogens, drug development, vaccination processes, and the role of monoclonal antibodies in treatment. This summary covers key concepts such as antibiotics, drug testing, and plant disease defenses, making it essential for biology students preparing for exams.
Explore the key types of plant pathogens, including viruses, bacteria, fungi, and protists. This summary covers their impact on plant health, symptoms of infection, and the role of essential nutrients like magnesium and nitrogen in plant growth. Ideal for GCSE Biology students studying Infection and Response.
Explore key concepts of pathogens, their types, and how diseases spread and can be controlled. This summary covers bacteria, viruses, fungi, and protists, along with prevention methods like vaccination and hygiene. Ideal for Year 11 Science students preparing for exams.
Explore key concepts in infection and response, including the immune system, vaccination, and disease prevention. This comprehensive summary covers plant and human diseases, the role of pathogens, and the mechanisms of monoclonal antibodies. Ideal for AQA Biology students preparing for exams.
Explore key concepts in disease prevention, including biological defenses, vaccination methods, and antibiotic use. This summary covers the immune system's response to pathogens, the role of vaccines in public health, and the importance of antibiotics in treating bacterial infections. Ideal for AQA GCSE Biology students seeking to understand the mechanisms of disease control and treatment.
Comprehensive study notes covering key concepts in Infection and Response for GCSE AQA Biology. Explore topics such as antibiotics, viral and bacterial diseases, immune responses, and plant disease detection. Ideal for exam preparation and understanding disease prevention and treatment strategies.
App Store
Google Play
The app is very easy to use and well designed. I have found everything I was looking for so far and have been able to learn a lot from the presentations! I will definitely use the app for a class assignment! And of course it also helps a lot as an inspiration.
Stefan S
iOS user
This app is really great. There are so many study notes and help [...]. My problem subject is French, for example, and the app has so many options for help. Thanks to this app, I have improved my French. I would recommend it to anyone.
Samantha Klich
Android user
Wow, I am really amazed. I just tried the app because I've seen it advertised many times and was absolutely stunned. This app is THE HELP you want for school and above all, it offers so many things, such as workouts and fact sheets, which have been VERY helpful to me personally.
Anna
iOS user
Best app on earth! no words because it’s too good
Thomas R
iOS user
Just amazing. Let's me revise 10x better, this app is a quick 10/10. I highly recommend it to anyone. I can watch and search for notes. I can save them in the subject folder. I can revise it any time when I come back. If you haven't tried this app, you're really missing out.
Basil
Android user
This app has made me feel so much more confident in my exam prep, not only through boosting my own self confidence through the features that allow you to connect with others and feel less alone, but also through the way the app itself is centred around making you feel better. It is easy to navigate, fun to use, and helpful to anyone struggling in absolutely any way.
David K
iOS user
The app's just great! All I have to do is enter the topic in the search bar and I get the response real fast. I don't have to watch 10 YouTube videos to understand something, so I'm saving my time. Highly recommended!
Sudenaz Ocak
Android user
In school I was really bad at maths but thanks to the app, I am doing better now. I am so grateful that you made the app.
Greenlight Bonnie
Android user
very reliable app to help and grow your ideas of Maths, English and other related topics in your works. please use this app if your struggling in areas, this app is key for that. wish I'd of done a review before. and it's also free so don't worry about that.
Rohan U
Android user
I know a lot of apps use fake accounts to boost their reviews but this app deserves it all. Originally I was getting 4 in my English exams and this time I got a grade 7. I didn’t even know about this app three days until the exam and it has helped A LOT. Please actually trust me and use it as I’m sure you too will see developments.
Xander S
iOS user
THE QUIZES AND FLASHCARDS ARE SO USEFUL AND I LOVE Knowunity AI. IT ALSO IS LITREALLY LIKE CHATGPT BUT SMARTER!! HELPED ME WITH MY MASCARA PROBLEMS TOO!! AS WELL AS MY REAL SUBJECTS ! DUHHH 😍😁😲🤑💗✨🎀😮
Elisha
iOS user
This apps acc the goat. I find revision so boring but this app makes it so easy to organize it all and then you can ask the freeeee ai to test yourself so good and you can easily upload your own stuff. highly recommend as someone taking mocks now
Paul T
iOS user
The app is very easy to use and well designed. I have found everything I was looking for so far and have been able to learn a lot from the presentations! I will definitely use the app for a class assignment! And of course it also helps a lot as an inspiration.
Stefan S
iOS user
This app is really great. There are so many study notes and help [...]. My problem subject is French, for example, and the app has so many options for help. Thanks to this app, I have improved my French. I would recommend it to anyone.
Samantha Klich
Android user
Wow, I am really amazed. I just tried the app because I've seen it advertised many times and was absolutely stunned. This app is THE HELP you want for school and above all, it offers so many things, such as workouts and fact sheets, which have been VERY helpful to me personally.
Anna
iOS user
Best app on earth! no words because it’s too good
Thomas R
iOS user
Just amazing. Let's me revise 10x better, this app is a quick 10/10. I highly recommend it to anyone. I can watch and search for notes. I can save them in the subject folder. I can revise it any time when I come back. If you haven't tried this app, you're really missing out.
Basil
Android user
This app has made me feel so much more confident in my exam prep, not only through boosting my own self confidence through the features that allow you to connect with others and feel less alone, but also through the way the app itself is centred around making you feel better. It is easy to navigate, fun to use, and helpful to anyone struggling in absolutely any way.
David K
iOS user
The app's just great! All I have to do is enter the topic in the search bar and I get the response real fast. I don't have to watch 10 YouTube videos to understand something, so I'm saving my time. Highly recommended!
Sudenaz Ocak
Android user
In school I was really bad at maths but thanks to the app, I am doing better now. I am so grateful that you made the app.
Greenlight Bonnie
Android user
very reliable app to help and grow your ideas of Maths, English and other related topics in your works. please use this app if your struggling in areas, this app is key for that. wish I'd of done a review before. and it's also free so don't worry about that.
Rohan U
Android user
I know a lot of apps use fake accounts to boost their reviews but this app deserves it all. Originally I was getting 4 in my English exams and this time I got a grade 7. I didn’t even know about this app three days until the exam and it has helped A LOT. Please actually trust me and use it as I’m sure you too will see developments.
Xander S
iOS user
THE QUIZES AND FLASHCARDS ARE SO USEFUL AND I LOVE Knowunity AI. IT ALSO IS LITREALLY LIKE CHATGPT BUT SMARTER!! HELPED ME WITH MY MASCARA PROBLEMS TOO!! AS WELL AS MY REAL SUBJECTS ! DUHHH 😍😁😲🤑💗✨🎀😮
Elisha
iOS user
This apps acc the goat. I find revision so boring but this app makes it so easy to organize it all and then you can ask the freeeee ai to test yourself so good and you can easily upload your own stuff. highly recommend as someone taking mocks now
Paul T
iOS user